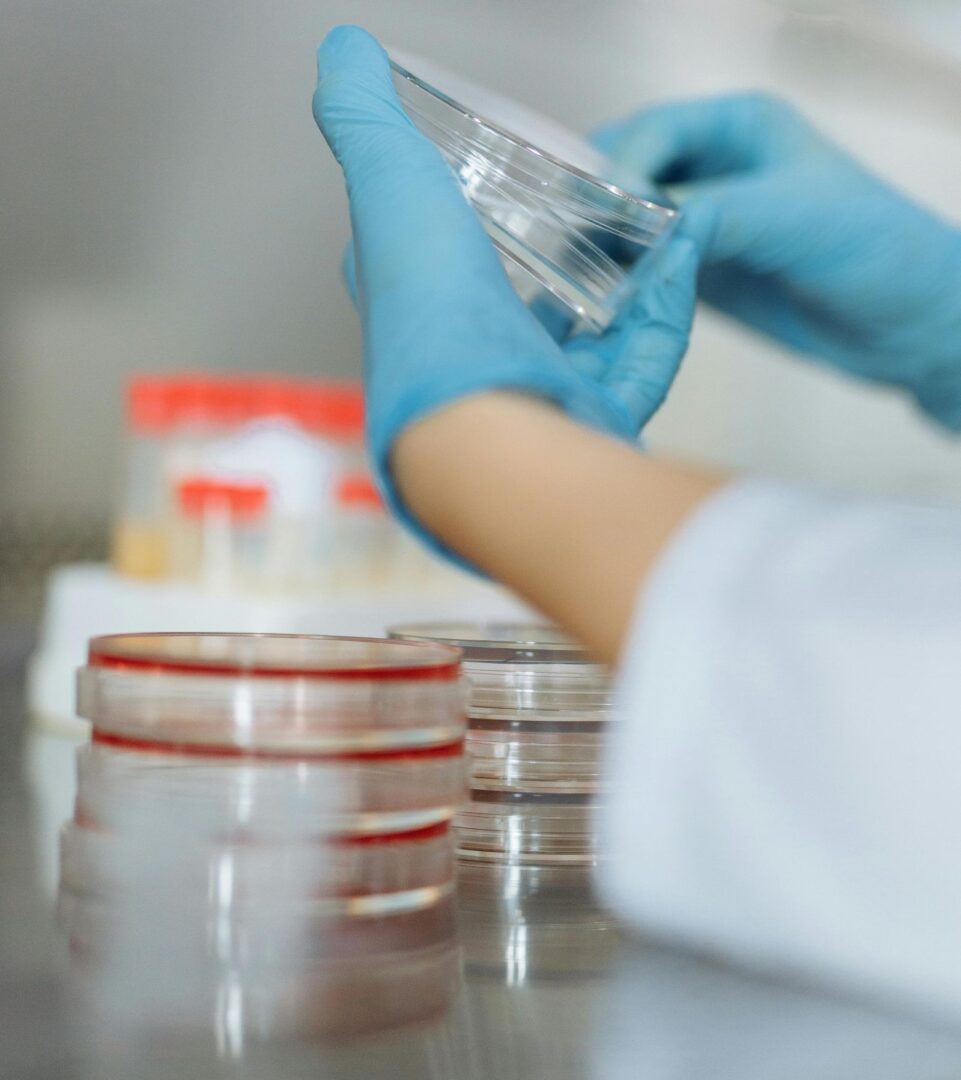
Fertilización

En un mundo donde los sueños de ser padres a veces parecen inalcanzables, la historia de la fertilización in vitro (IVF) surge como un faro de esperanza. Desde su nacimiento en 1978, esta técnica ha transformado la vida de millones de familias alrededor del mundo, ofreciendo una segunda oportunidad a quienes enfrentan desafíos de fertilidad. Pero detrás de este avance monumental se encuentra una historia de perseverancia, innovación y un compromiso inquebrantable con la vida.
El Nacimiento de una Revolución
El 25 de julio de 1978, el mundo fue testigo de un acontecimiento que cambiaría para siempre el rumbo de la medicina reproductiva: el nacimiento de Louise Brown, la primera niña concebida mediante fertilización in vitro. Este hito no solo representó un avance científico, sino que se convirtió en un símbolo de esperanza para parejas que habían luchado durante años contra la infertilidad. La historia de Louise es la de un milagro, pero también la de un trabajo arduo y una visión que desafiaba las convenciones de la época.
La técnica de la IVF fue desarrollada por los doctores Robert Edwards y Patrick Steptoe en el Reino Unido, quienes enfrentaron escepticismo y resistencia en su búsqueda por ayudar a las parejas a concebir. Su trabajo pionero fue un testimonio del poder de la ciencia y la determinación humana. La fertilización in vitro no solo abrió la puerta a nuevas posibilidades, sino que también sentó las bases para futuras investigaciones y desarrollos en el campo de la reproducción asistida.
Pionero en Guatemala
En Guatemala, la historia de la fertilización in vitro encontró un defensor inquebrantable en el Dr. Haroldo López. Desde sus inicios, el Dr. López se sintió llamado a transformar la vida de las parejas que enfrentaban la infertilidad. En 1976, gestionó la creación de la primera clínica de fertilidad en el Hospital San Juan de Dios, marcando un hito pionero en el país. Sin embargo, fue en 1989 cuando realizó el primer procedimiento de fertilización in vitro en Guatemala, un logro que abrió las puertas a una nueva era en los tratamientos de reproducción asistida.
En un contexto donde Guatemala carecía de medicamentos y tecnología adecuados para estos procedimientos, el Dr. López forjó alianzas internacionales que hicieron posible convertir su sueño en realidad. Su dedicación y pasión por ayudar a las parejas a formar familias lo llevaron a enfrentar numerosos desafíos, pero su compromiso siempre fue firme. “Cada tratamiento representa mucho más que un procedimiento médico; es dar una nueva oportunidad al sueño de ser padres”, solía decir.
El Dr. López no solo fue un pionero en la medicina reproductiva, sino también un mentor para muchos especialistas en fertilidad que han pasado por su institución. Su visión y liderazgo han dejado una huella imborrable en el campo de la reproducción asistida en Guatemala y Centroamérica.
La historia de la fertilización in vitro en Guatemala no estaría completa sin mencionar el papel fundamental del Centro de Reproducción Humana (CER). Fundado en 1997 por el Dr. Haroldo López, CER se estableció como el primer centro en el país con un laboratorio especializado en fertilización in vitro. Desde entonces, ha sido sinónimo de innovación, experiencia y un compromiso inquebrantable con aquellas parejas que buscan cumplir su sueño de formar una familia.

Entre las tecnologías avanzadas que utiliza CER se encuentran el sistema RI Witness, que garantiza la trazabilidad de cada muestra, y la vitrificación avanzada de óvulos y embriones. Estas innovaciones no solo aumentan las tasas de éxito de los tratamientos, sino que también aseguran la seguridad en cada etapa del proceso.

Un Compromiso con el Futuro
Hoy, mientras se celebra el 47 aniversario del nacimiento de la primera niña concebida por fertilización in vitro, CER continúa siendo un faro de esperanza en Guatemala. El Dr. Haroldo López y su equipo han dedicado sus vidas a transformar la medicina reproductiva, y su legado sigue vivo en cada historia de éxito.
“Para nosotros, cada tratamiento es más que un procedimiento; es un viaje lleno de emociones, anhelos y valentía”, dice Vivian López, gerente general de CER. “Agradecemos la confianza que cada paciente deposita en nosotros. Celebramos la vida y la ciencia, y nos comprometemos a seguir ofreciendo las mejores soluciones en reproducción asistida”.
La historia de la fertilización in vitro es una historia de esperanza, innovación y amor. Por este método, se ayuda a las familias a transformar sus sueños en realidad.
También podría interesarte: Autismo en Guatemala: del silencio a la acción comunitaria